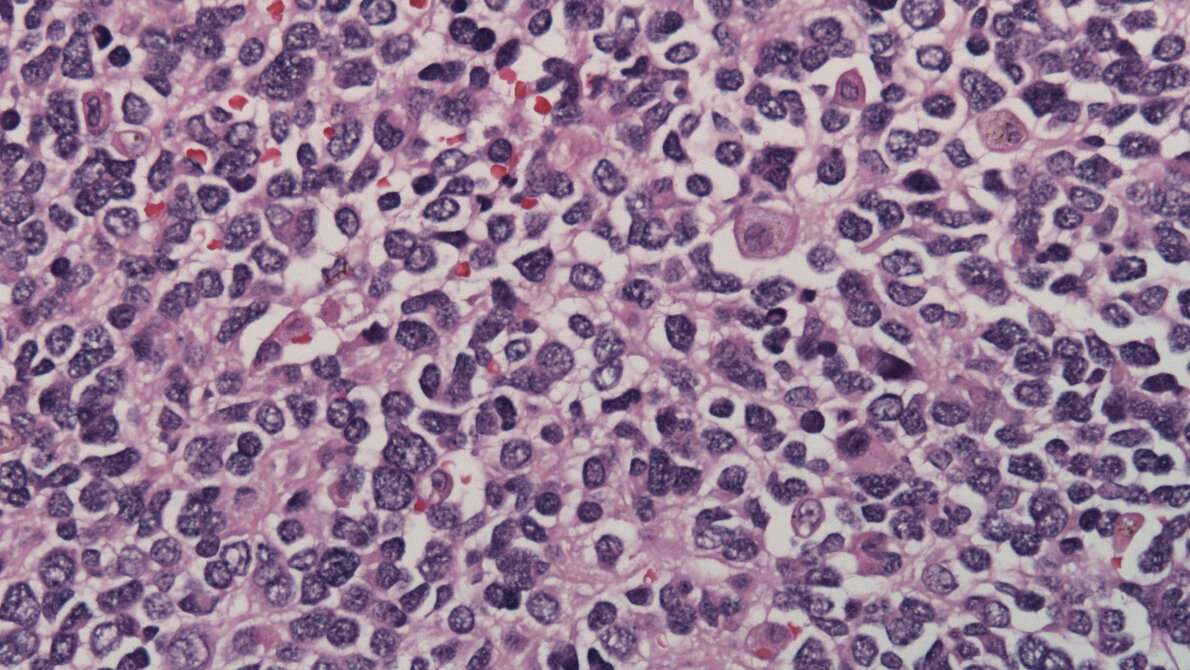
Neuroblastom

Mit 7-8 Prozent ist das Neuroblastom der dritthäufigste Tumor im Kindesalter außerhalb des Gehirns. Es entsteht aus neuralen Zellen in Nervenknoten des sympathischen Nervensystems und in der Nebenniere, die sich aus bisher nur ansatzweise geklärter Ursache ungehindert vermehren. Aggressive Varianten des Neuroblastoms sind gegen die bislang verfügbaren Therapien weitestgehend resistent und die daran erkrankten Kinder haben nur geringe Überlebenschancen.
Die entwicklungsbiologische Forschung des Teams um Prof. Hermann Rohrer stellte es sich zur Aufgabe, eine molekulare Erklärung für die Tumorentstehung zu finden und damit neue Möglichkeiten zur Hemmung des Tumorwachstums zu finden. Dabei konnten sie einen wichtigen Prozess in der Tumorentstehung aufklären.
Entwicklung der Neuroblastome
Wie bei allen Tumoren, die nur im Kindesalter auftreten, besteht ein Zusammenhang zwischen entwicklungsspezifischen Vorgängen und der Entstehung des Neuroblastoms. Dies war der Ausgangspunkt des Projektes von Prof. Rohrer. Im Vordergrund standen vor allem die grundlegenden Mechanismen, die im Neuroblastom zur gestörten Entwicklung sympathischer Vorläuferzellen (sog. Neuroblasten) führen. Dabei teilen sie sich vermehrt und entwickeln sich danach zu Tumorzellen. Es sind bereits mehrere Gene bekannt (u.a. MYCN, ALK, Lin28B), die im Neuroblastom genetisch verändert und an der Tumorentstehung beteiligt sind. Neben der normalen Funktion dieser Proteine untersuchten die Wissenschaftler daher auch die Effekte der mutierten Varianten.
Wie bei Mäusen bereits festgestellt wurde, kann der Neuroblastom-Tumor durch die Überproduktion des MYCN-Proteins und der aktivierten Tyrosinkinase ALK (aALK) in sympathischen Ganglien ausgelöst werden. Liegen MYCN und aALK gemeinsam in Vorläuferzellen vor, wird das Wachstum des Neuroblastoms verstärkt und beschleunigt. Dies hatte die Forschergruppe von Prof. Rohrer in Zusammenarbeit mit Dr. Janoueix-Lerosey und Prof. Delattre am Institut Curie in Paris in einer vorherigen Studie bereits gezeigt. Für die neue Studie wurden MYCN und aALK in vitro in Kulturen von sympathischen Neuroblasten exprimiert, um die Kooperation dieser beiden Gene besser zu verstehen.
Wichtige Rolle von SKP2
Eine erhöhte Produktion von MYCN stimuliert zunächst das Zellwachstum, führt aber auch zum vermehrten Zelltod. Wenn aALK und MYCN aber gemeinsam in Neuroblasten eingebracht werden, verhindert aALK den Zelltod und die Anzahl der Zellen nimmt konstant zu. Ein Nebenprodukt dieser Bedingungen ist das Protein SKP2. Dieses Protein verhindert wiederum, dass die Neuroblasten den Zellzyklus verlassen. Das Zellwachstum der MYCN/aALK exprimierenden Neuroblasten konnte vollständig blockiert werden durch die pharmakologische Hemmung der Funktion von SKP2. Die Forscher gehen davon aus, dass SKP2 sowohl bei der Tumorentstehung und auch beim Tumorwachstum eine wichtige Rolle spielt. Die Produktion von SKP2 steht unter der Kontrolle von MYCN und ist speziell in aggressiven Varianten des Neuroblastoms stark erhöht.
Quelle: Wilhelm-Sander-Stiftung, 14.02.2017
Artikel teilen